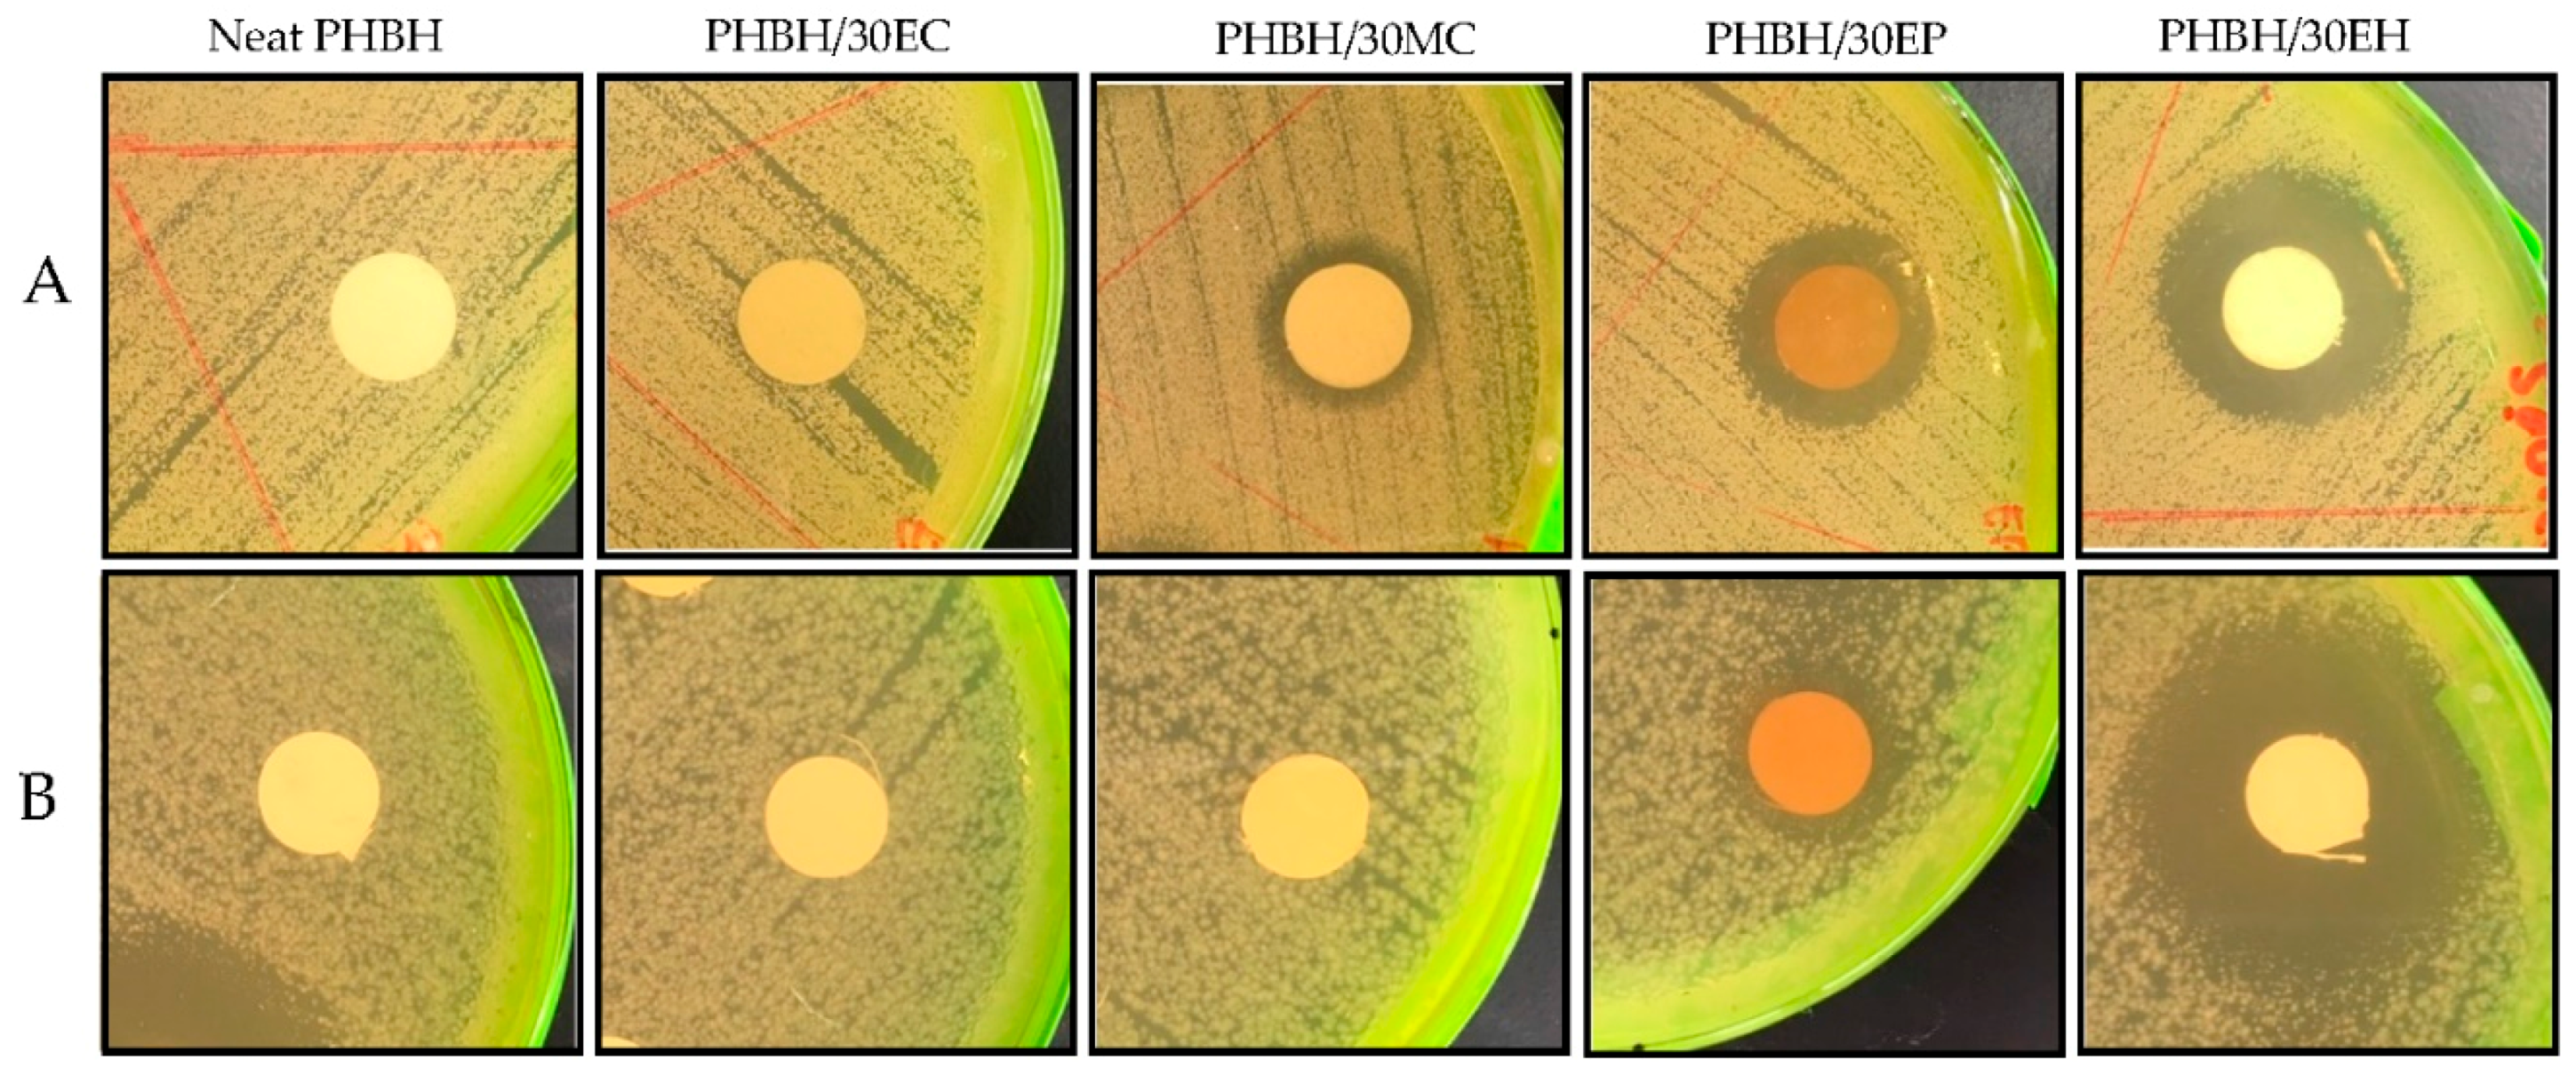
Nanomaterials 09 01665 g005

Natural Antibacterial Reagents (Centella, Propolis, and Hinokitiol) Loaded into Poly[(R)-3-hydroxybutyrate-co-(R)-3-hydroxyhexanoate] Composite Nanofibers for Biomedical Applications
Abstract
1. Introduction
2. Materials and Methods
2.1. Materials
2.2. Electrospinning Process of PHBH Composite Nanofibers Containing the Natural Antibacterial Reagents
2.2.1. Preparation of Natural Antibacterial Reagent Solutions
2.2.2. Preparation of PHBH with Natural Antibacterial Reagent Solutions for Electrospinning
2.3. Characterization of PHBH Composite Nanofibers with Natural Antibacterial Reagent
2.3.1. Scanning Electron Microscopy (SEM)
2.3.2. Fourier Transform Infrared (FT-IR) Spectroscopy
2.3.3. X-ray Diffraction
2.3.4. Mechanical Properties
2.4. Sustained Release Behavior of Natural Antibacterial Reagent from PHBH Composite Nanofibers
2.5. Antibacterial Activity Test
2.6. Statistical Analysis
3. Results and Discussion
3.1. Morphology of PHBH Composite Nanofibers with Natural Antibacterial Reagents
3.2. Characteristic of PHBH Composite Nanofibers with Natural Antibacterial Product
3.2.1. FT-IR Spectral Analysis
3.2.2. Crystalline Structure by Wide-Angle X-ray Diffraction (WAXD)
3.2.3. Mechanical Characteristic of Composite Nanofibers
3.3. In Vitro Antibacterial Activity
3.4. Release Behavior of Natural Antibacterial Product
4. Conclusions
Author Contributions
Funding
Acknowledgments
Conflicts of Interest
References
- Sh Asran, A.; Razghandi, K.; Aggarwal, N.; Michler, G.H.; Groth, T. Nanofibers from blends of polyvinyl alcohol and polyhydroxy butyrate as potential scaffold material for tissue engineering of skin. Biomacromolecules 2011, 11, 3413–3421. [Google Scholar] [CrossRef] [PubMed]
- Asawahame, C.; Sutjarittangtham, K.; Eitssayeam, S.; Tragoolpua, Y.; Sirithunyalung, B.; Sirithunyalug, J. Antibacterial activity and inhibition of adherence of Streptococcus mutans by propolis electrospun fibers. AAPS Pharm. Sci. Tech. 2015, 16, 182–191. [Google Scholar] [CrossRef] [PubMed]
- Lee, H.S.; Lee, S.Y.; Park, S.H.; Lee, J.H.; Ahn, S.K.; Choi, Y.M.; Choi, D.J.; Chang, J.H. Antimicrobial medical sutures with caffeic acid phenethyl ester and their in vitro/in vivo biological assessment. Med. Chem. Commun. 2013, 4, 777–782. [Google Scholar] [CrossRef]
- Rebia, R.A.; Rozet, S.; Tamada, Y.; Tanaka, T. Biodegradable PHBH/PVA blend nanofibers: Fabrication, characterization, in vitro degradation, and in vitro biocompatibility. Polym. Degrad. Stab. 2018, 154, 124–136. [Google Scholar] [CrossRef]
- Manotham, S.; Pengpat, K.; Eitssayeam, S.; Rujijanagul, G.; Sweatmam, D.R.; Tunkasiri, T. Fabrication of Polycaprolactone/Centella asiatica Extract Biopolymer Nanofiber by Electrospinning. Appl. Mech. Mater. 2015, 804, 151–154. [Google Scholar] [CrossRef]
- Philip, S.; Keshavarz, T.; Roy, I. Polyhydroxyalkanoates: Biodegradable polymers with a range of applications. J. Chem. Technol. Biotechnol 2007, 82, 233–247. [Google Scholar] [CrossRef]
- Ignatova, M.G.; Manolova, N.E.; Rashkov, L.B.; Markova, N.D.; Toshkova, R.A.; Georgieva, A.K.; Nikolova, E.B. Poly(3-hydroxybutyrate)/caffeic acid electrospun fibrous material coated with polyelectrolyte complex and their antibacterial activity and in vitro antitumor effect against HeLa cells. Mater. Sci. Eng. C Mater. 2016, 65, 379–392. [Google Scholar] [CrossRef]
- Bulman, S.E.L.; Goswami, P.; Tronci, G.; Russell, S.J.; Carr, C. Investigation into the potential use of poly (vinyl alcohol)/methylglyoxal fibres as antibacterial wound dressing components. J. Biomater. Appl. 2015, 8, 1198–1200. [Google Scholar] [CrossRef]
- Gun, J.; Zhang, M. Polyblend nanofibers for biomedical applications: Perspectives and challenges. Cell Press 2010, 28, 189–197. [Google Scholar] [CrossRef]
- Scaffaro, R.; Lopresti, F. Processing, structure, property relationships and release kinetics of electrospun PLA/Carvacrol membranes. Eur. Polym. J. 2018, 100, 165–171. [Google Scholar] [CrossRef]
- Mutlu, G.; Calamak, S.; Ulubayram, K.; Guven, E. Curcumin-loaded electrospun PHBV nanofibers as potential wound-dressing material. J. Drug Deliv. Sci. Technol. 2018, 43, 185–193. [Google Scholar] [CrossRef]
- Andreau, V.; Mendoza, G.; Arruebo, M.; Irusta, S. Review: Smart dressings based on nanostructured fibers containing natural original antimicrobial, anti-inflammatory, and regenerative compounds. Material 2015, 8, 5154–5193. [Google Scholar] [CrossRef] [PubMed]
- Kwon, M.C.; Choi, W.Y.; Seo, Y.C.; Kim, J.S.; Yoon, C.S.; Lim, H.W.; Kim, H.S.; Ahn, J.H.; Lee, H.Y. Enhancement of the skin-protective activities of Centella asiatica L. Urban by a nano-encapsulation process. J. Biotechnol. 2012, 157, 100–106. [Google Scholar] [CrossRef] [PubMed]
- Yao, C.H.; Yeh, J.Y.; Chen, Y.S.; Li, M.H.; Huang, C.H. Wound-healing effect of electrospun gelatin nanofibres containing Centella asiatica extract in a rat model. J. Tissue Eng. Regen. Med. 2017, 11, 905–915. [Google Scholar] [CrossRef]
- Sikareepaisan, P.; Suksamrarn, A.; Supaphol, P. Electrospun gelatin fiber mats containing a herbal-Centella asiatica-extract and release characteristic of asiatocoside. Nanotechnology 2008, 19, 015102. [Google Scholar] [CrossRef]
- Azis, H.A.; Taher, M.; Ahmed, A.S.; Sulaiman, W.M.A.W.; Susanti, D.; Chowdhury, S.R.; Zakaria, Z.A. In vitro and In vivo wound healing studies of methanolic fraction of Centella asiatica extract. S. Afr. J. Bot. 2017, 108, 163–174. [Google Scholar] [CrossRef]
- Lima, G.G.; Souza, R.O.; Bozzi, A.D.; Poplawska, M.A.; Devine, D.M.; Nugent, M.J.D. Extraction Method Plays Critical Role in Antibacterial Activity of Propolis-Loaded Hydrogels. J. Pharm. Sci. 2016, 105, 1–10. [Google Scholar]
- Adomavičiūtė, E.; Stanys, S.; Žilius, M.; Juškaitė, V.; Pavilonis, A.; Briedis, V. Formation and biopharmaceutical characterization of electrospun PVP mats with propolis and silver nanoparticles for fast releasing wound dressing. Biomed. Res. Int. 2016. [Google Scholar] [CrossRef]
- Wang, J.; Vermerris, W. Antimicrobial nanomaterials derived from natural products—A review. Material 2016, 9, 255. [Google Scholar] [CrossRef]
- Kim, J.I.; Pant, H.R.; Sim, H.J.; Lee, K.M.; Kim, C.S. Electrospun propolis/polyurethane composite nanofibers for biomedical applications. Mater. Sci. Eng. C Mater. 2014, 44, 52–57. [Google Scholar] [CrossRef]
- Zeighampour, F.; Alihosseini, F.; Morshed, M.; Rahimi, A.A. Comparison of prolonged antibacterial activity and release profile of propolis-incorporated PVA nanofibrous mat, microfibrous mat, and film. J. Appl. Polym. Sci. 2018, 135, 45794. [Google Scholar] [CrossRef]
- Paul, S.; Emmanuel, T.; Matchawe, C.; Alembert, T.T.; Elisabeth, Z.M.; Sophie, L.; Luce, V.E.; Maurice, T.F.; Joel, Y.G.A.; Alex, A.D.T.; et al. Pentacyclic triterpenes and crude extracts with antimicrobial activity from Cameroonian brown propolis samples. J. Appl. Pharm. Sci. 2014, 4, 1–9. [Google Scholar]
- Dyrskov, L.; Strobel, B.W.; Svensmark, B.; Hansen, H.C.B. β-Thujaplicin: New Quantitative CZE Method and Adsorption to Goethite. J. Agric. Food Chem. 2004, 52, 1452–1457. [Google Scholar] [CrossRef] [PubMed]
- Shih, Y.-H.; Lin, D.-J.; Chang, K.-W.; Hsia, S.-M.; Ko, S.-Y.; Lee, S.-Y.; Hsue, S.-S.; Wang, T.-H.; Chen, Y.-L.; Shieh, T.-M. Evaluation physical characteristics and comparison antimicrobial and anti-inflammation potentials of dental root canal sealers containing hinokitiol in vitro. PLoS ONE 2014, 9, e94941. [Google Scholar] [CrossRef] [PubMed]
- Hosoda, N.; Tsujimoto, T.; Uyama, H. Green composite of poly (3-hydroxybutyrate-co-3-hydroxyhexanoate) reinforced with porous cellulose. ACS Sustain. Chem. Eng. 2014, 2, 248–253. [Google Scholar] [CrossRef]
- Bugnicourt, E.; Cinelli, P.; Lazzeri, A.; Alvare, V. Polyhydroxyalkanoate (PHA): Review of synthesis, characteristics, processing and potential applications in packaging. Express Polym. Lett. 2014, 8, 791–808. [Google Scholar] [CrossRef]
- Iwata, T.; Tsuge, T.; Taguchi, S.; Abe, H.; Tanaka, T. Bio-Polyesters. In Bio-Based Polymers, 1st ed.; Kimura, Y., Ed.; CMC Publishing Co., Ltd.: Tokyo, Japan, 2013; pp. 71–85. ISBN 978-4-7813-0271-3. [Google Scholar]
- Lu, X.; Wang, L.; Yang, Z.; Lu, H. Strategies of polyhydroxyalkanoates modification for the medical application in neural regeneration/nerve tissue engineering. Adv. Biosci. Biotechnol. 2013, 4, 731–740. [Google Scholar] [CrossRef][Green Version]
- Lee, S.Y. Bacterial polyhydroxyalkanoates. Biotechnol. Bioeng. 1996, 49, 1–14. [Google Scholar] [CrossRef]
- Ignatova, M.; Manolova, N.; Rashkov, I.; Markova, N. Quaternized chitosan/κ-carrageenan/caffeic acid-coated poly(3-hydroxybutyrate) fibrous materials: Preparation, antibacterial and antioxidant activity. Int. J. Pharm. 2016, 513, 528–537. [Google Scholar] [CrossRef]
- Phan, D.-N.; Dorjjugder, N.; Khan, M.Q.; Saito, Y.; Taguchi, G.; Lee, H.; Mukai, Y.; Kim, I.-S. Synthesis and attachment of silver and copper nanoparticles on cellulose nanofibers and comparative antibacterial study. Cellulose 2019, 26, 6629–6640. [Google Scholar] [CrossRef]
- Phan, D.-N.; Dorjjugder, N.; Saito, Y.; Taguchi, G.; Lee, H.; Lee, J.S.; Kim, I.-S. The mechanistic actions of different silver species at the surfaces of polyacrylonitrile nanofibers regarding antibacterial activities. Mater. Today Commun. 2019, in press. [Google Scholar] [CrossRef]
- Sharaf, S.; El-Naggar, M.E. Eco-friendly technology for preparation, characterization and promotion of honey bee propolis extract loaded cellulose acetate nanofibers in medical domains. Cellulose 2018, 25, 5195–5204. [Google Scholar] [CrossRef]
- Sondari, D.; Harmami, S.B.; Ghozali, M.; Randy, A.; Amanda-S, A.; Irawan, Y. Determination of the active asiaticoside content in centella asiatica as anti-cellulite agent. Indones. J. Cancer Chemoprevent. 2011, 2, 222–227. [Google Scholar] [CrossRef][Green Version]
- Sugunabai, J.; Jeyaraj, M.; Karpagam, T. Analysis of functional compounds and antioxidant activity of centella asiatica. World J. Pharm. Pharm. Sci. 2015, 4, 1982–1993. [Google Scholar]
- Oliveira, R.N.; Mancini, M.C.; Oliveira, F.C.S.; Passos, T.M.; Quilty, B.; Thiré, R.M.S.; McGuinness, G.B. FTIR analysis and quantification of phenols and flavonoids of five commercially available plants extracts used in wound healing. Rev. Mater. 2016, 21, 767–779. [Google Scholar] [CrossRef]
- Ikegami, Y. The infrared spectra of troponoid compounds. VI. The infrared and Raman spectra of tropolone, 3- and 4-isopropyltropolones. Bull. Chem. Soc. Jpn. 1963, 36, 1118–1125. [Google Scholar] [CrossRef]
- Ying, T.H.; Ishii, D.; Mahara, A.; Murakami, S.; Yamaoka, T.; Sudesh, K.; Samian, R.; Fujita, M.; Maeda, M.; Iwata, T. Scaffolds from electrospun polyhydroxyalkanoate copolymers: Fabrication, characterization, bioabsorption and tissue response. Biomaterials 2008, 29, 1307–1317. [Google Scholar] [CrossRef]
- Kim, Y.-J.; Park, M.R.; Kim, M.S.; Kwon, O.H. Polyphenol-loaded polycaprolactone nanofibers for effective growth inhibition of human cancer cells. Mater. Chem. Phys. 2012, 133, 674–680. [Google Scholar] [CrossRef]
- Moradkhannejhad, L.; Abdouss, M.; Nikfarjam, N.; Mazinani, S.; Heydari, V. Electrospinning of zein/propolis nanofibers; antimicrobial properties and morphology investigation. J. Mater. Sci. Mater. Med. 2018, 29, 165–175. [Google Scholar] [CrossRef]
- Klančnik, A.; Piskernik, S.; Jeršek, B.; Možina, S.S. Evaluation of diffusion and dilution methods to determine the antibacterial activity of plant extracts. J. Microbiol. Methods 2010, 81, 121–126. [Google Scholar] [CrossRef]
- Kyziol, A.; Michna, J.; Moreno, I.; gemez, E.; Irusta, S. Preparation and characterization of electrospun alginate nanofibers loaded with ciprofloxacin hydrochloride. Eur. Polym. J. 2017, 96, 350–360. [Google Scholar] [CrossRef]
- Sohrabi, A.; Shaibani, P.M.; Etayash, H.; Kaur, K.; Thundat, T. Sustained drug release and antibacterial activity of ampicillin incorporated poly (methyl methacrylate)enylon6 core/shell nanofibers. Polymer 2013, 54, 2699–2705. [Google Scholar] [CrossRef]
- Ignatova, M.; Manolova, N.; Rashkov, I.; Markova, N.D. Antibacterial and antioxidant electrospun materials from Poly(3-hydroxybutyrate) and polyvinylpyrrolidone containing caffeic acid phenethyl ester-“in” and “on” strategies for enhanced solubility. Int. J. Pharm. 2018, 545, 342–356. [Google Scholar] [CrossRef] [PubMed]

| Concentration(w/v)_Solution_Natural Product (NP) | Percentage Concentration of NP Inside Solution (w/w) | Ratios NP Solutions over Total Weight of Spinning PHBH Solutions (v/v) (Code) | |||
|---|---|---|---|---|---|
| 1% | 5% | 7% | 10% | ||
| 15% Ethanol–Centella | 2.16% | 15EC (1%) | 15EC (5%) | - | 15EC (10%) |
| 30% Ethanol–Centella | 4.14% | 30EC (1%) | 30EC (5%) | - | 30EC (10%) |
| 15% Methanol–Centella | 3.17% | 15MC (1%) | 15MC (5%) | - | 15MC (10%) |
| 30% Methanol–Centella | 7.21% | 30MC (1%) | 30MC (5%) | - | 30MC (10%) |
| 10% Acetone–Propolis | 8.95% | 10AP (1%) | 10AP (5%) | 10AP (7%) | - |
| 10% Ethanol–Propolis | 5.43% | 10EP (1%) | 10EP (5%) | 10EP (7%) | - |
| 30% Ethanol–Propolis | 12.25% | 30EP (1%) | 30EP (5%) | 30EP (7%) | - |
| 30% Ethanol–Hinokitiol | 30% | 30EH (1%) | 30EH (5%) | 30EH (7%) | - |
| No. | Polymer | Ratio Concentration-Solvent-Natural Product-Ratio to PHBH Solutions | Electrospinning Conditions | Fiber Diameters | ||||
|---|---|---|---|---|---|---|---|---|
| Solvent-Natural Product | Ratios to PHBH Solutions (Code) | Applied Voltage (kV) | Flow Rate (mm/min) | Ave. Dia. (nm) ± SD | Max. | Min. | ||
| 1 | Neat PHBH | - | - | 20 | 0.3 | 543 | 785 | 367 |
| 2 | PHBH | 15% Ethanol–Centella (EC) | PHBH/15EC (1%) | 15.5 | 0.13 | 524 ± 111 | 760 | 230 |
| PHBH/15EC (5%) | 15.5 | 0.13 | 314 ± 116 | 631 | 157 | |||
| PHBH/15EC (10%) | 15.5 | 0.13 | 226 ± 77 | 413 | 107 | |||
| 3 | PHBH | 30% Ethanol–Centella (EC) | PHBH/30EC (1%) | 15.5 | 0.15–0.2 | 447 ± 128 | 789 | 255 |
| PHBH/30EC (5%) | 15.5 | 0.15–0.2 | 362 ± 107 | 690 | 131 | |||
| PHBH/30EC (10%) | 15.5 | 0.15–0.2 | 349 ± 108 | 593 | 153 | |||
| 4 | PHBH | 15% Methanol–Centella (MC) | PHBH/15MC (1%) | 15.5 | 0.15 | 319 ± 107 | 630 | 152 |
| PHBH/15MC (5%) | 15.5 | 0.15 | 310 ± 126 | 588 | 135 | |||
| PHBH/15MC (10%) | 15.5 | 0.15 | 227 ± 81 | 413 | 101 | |||
| 5 | PHBH | 30% Methanol–Centella (MC) | PHBH/30MC (1%) | 15.5 | 0.15–0.2 | 487 ± 127 | 820 | 238 |
| PHBH/30MC (5%) | 15.5 | 0.15–0.2 | 371 ± 83 | 571 | 194 | |||
| PHBH/30MC (10%) | 15.5 | 0.15–0.2 | 332 ± 62 | 456 | 236 | |||
| 6 | PHBH | 10% Acetone–Propolis (AP) | PHBH/10AP (1%) | 20 | 0.1 | 520 ± 83 | 717 | 374 |
| PHBH/10AP (5%) | 20 | 0.1 | 527 ± 161 | 978 | 286 | |||
| PHBH/10AP (7%) | 20 | 0.1 | 529 ± 109 | 890 | 328 | |||
| 7 | PHBH | 10% Ethanol–Propolis (EP) | PHBH/10EP (1%) | 20 | 0.1 | 548 ± 104 | 850 | 422 |
| PHBH/10EP (5%) | 20 | 0.1 | 576 ± 193 | 1192 | 289 | |||
| PHBH/10EP (7%) | 20 | 0.1 | 579 ± 126 | 884 | 338 | |||
| 8 | PHBH | 30% Ethanol–Propolis (EP) | PHBH/30EP (1%) | 20 | 0.15–0.2 | 539 ± 99 | 752 | 393 |
| PHBH/30EP (5%) | 20 | 0.15–0.2 | 653 ± 194 | 1180 | 300 | |||
| PHBH/30EP (7%) | 20 | 0.15–0.2 | 739 ± 197 | 1185 | 408 | |||
| 9 | PHBH | 30% Ethanol–Hinokitiol (EH) | PHBH/30EH (1%) | 20 | 0.15–0.2 | 562 ± 87 | 745 | 438 |
| PHBH/30EH (5%) | 20 | 0.15–0.2 | - | - | - | |||
| PHBH/30EH (7%) | 20 | 0.15–0.2 | - | - | - | |||
| Sample | Tensile Strength | Elongation at Break | Young’s Modulus | Crystallinity |
|---|---|---|---|---|
| (MPa) | (%) | (MPa) | (%) | |
| Neat PHBH | 8.00 ± 0.71 | 61.49 ± 17.38 | 291.5 ± 41.8 | 47.0 |
| PHBH/30EC (10%) | 17.79 ± 4.71 * | 15.57 ± 4.56 * | 420.4 ± 146.1 * | 55.0 |
| PHBH/30MC (10%) | 8.98 ± 1.47 | 10 ± 3.79 * | 291.7 ± 118.9 | 49.2 |
| PHBH/30EP (7%) | 16.35 ± 1.78 * | 9.27 ± 3.32 * | 545.6 ± 162.8 * | 54.5 |
| PHBH/30EH (1%) | 2.14 ± 0.70 * | 8.33 ± 1.75 * | 78 ± 33.8 * | 44.1 |
| Sample | Inhibition Zones (mm) | |
|---|---|---|
| S. aureus | E. coli | |
| Neat PHBH | 0 | 0 |
| PHBH/30EC (10%) | 0 | 0 |
| PHBH/30MC (10%) | 7.7 ± 6.7 | 0 |
| PHBH/30EP (7%) | 18.3 ± 1.5 * | 17.3 ± 5.1 * |
| PHBH/30EH (1%) | 25.7 ± 4.0 * | 29.7 ± 1.5 * |
© 2019 by the authors. Licensee MDPI, Basel, Switzerland. This article is an open access article distributed under the terms and conditions of the Creative Commons Attribution (CC BY) license (http://creativecommons.org/licenses/by/4.0/).
Share and Cite
Rebia, R.A.; binti Sadon, N.S.; Tanaka, T. Natural Antibacterial Reagents (Centella, Propolis, and Hinokitiol) Loaded into Poly[(R)-3-hydroxybutyrate-co-(R)-3-hydroxyhexanoate] Composite Nanofibers for Biomedical Applications. Nanomaterials 2019, 9, 1665. https://doi.org/10.3390/nano9121665
Rebia RA, binti Sadon NS, Tanaka T. Natural Antibacterial Reagents (Centella, Propolis, and Hinokitiol) Loaded into Poly[(R)-3-hydroxybutyrate-co-(R)-3-hydroxyhexanoate] Composite Nanofibers for Biomedical Applications. Nanomaterials. 2019; 9(12):1665. https://doi.org/10.3390/nano9121665
Chicago/Turabian StyleRebia, Rina Afiani, Nurul Shaheera binti Sadon, and Toshihisa Tanaka. 2019. "Natural Antibacterial Reagents (Centella, Propolis, and Hinokitiol) Loaded into Poly[(R)-3-hydroxybutyrate-co-(R)-3-hydroxyhexanoate] Composite Nanofibers for Biomedical Applications" Nanomaterials 9, no. 12: 1665. https://doi.org/10.3390/nano9121665
APA StyleRebia, R. A., binti Sadon, N. S., & Tanaka, T. (2019). Natural Antibacterial Reagents (Centella, Propolis, and Hinokitiol) Loaded into Poly[(R)-3-hydroxybutyrate-co-(R)-3-hydroxyhexanoate] Composite Nanofibers for Biomedical Applications. Nanomaterials, 9(12), 1665. https://doi.org/10.3390/nano9121665
